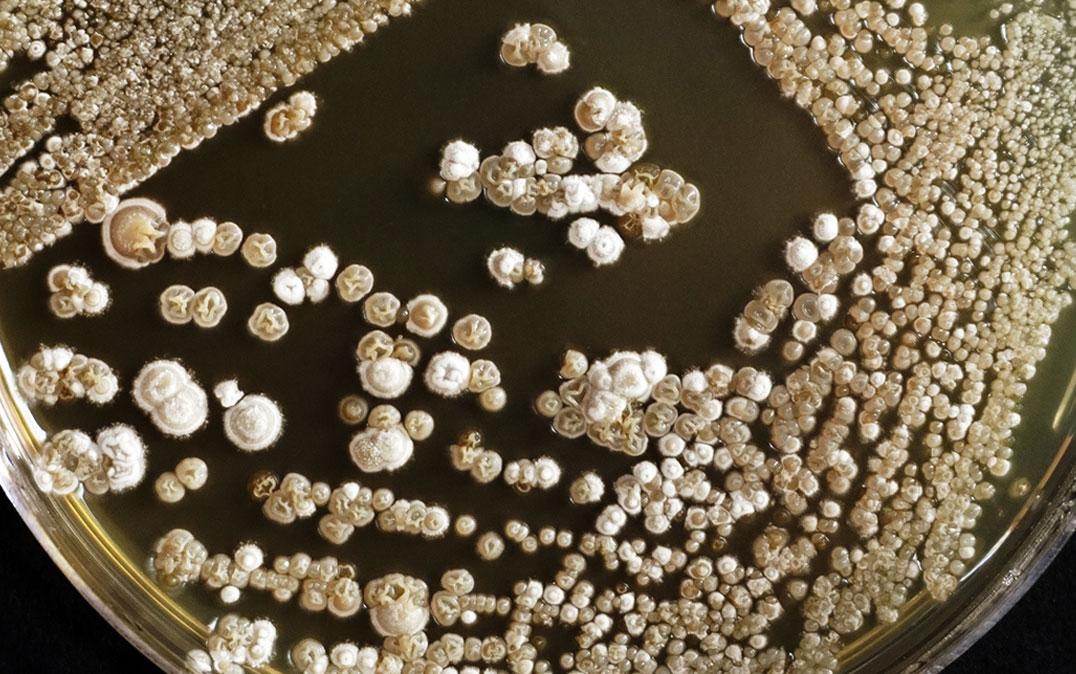
研究イメージ画像

生物・環境
宿主内に保存されたウイルス残骸の役割を解明
(Image by AjayTvm/Shutterstock)
(Image by AjayTvm/Shutterstock)
細菌に感染する⼀般的なウイルス(ファージ)の粒⼦は、遺伝物質を格納する頭部とそれを細菌細胞に打ち込む尾部からなります。ファージは、細菌細胞の遺伝情報の中に⾃らの遺伝情報を組み込み(感染)、これを宿主細菌に合成させることで増殖します。⼀⽅で、幅広い細菌群が、頭部を⽋いた尾部のみのファージ粒⼦に似た構造体を作ることが明らかになりつつありますが、このような粒⼦にどのような役割があるのかは分かっておらず、それらが細菌の進化の過程で保存されてきた理由はほとんど不明のままです。
本研究では、代表的な放線菌Streptomyces lividans(S. lividans)が作るファージ尾部様粒⼦(SLP)の役割の⼀端を明らかにしました。遺伝⼦変異によりSLP を⽋損させたS. lividans は、通常の培養条件では、その性状に明らかな変化はありませんでしたが、⾼い浸透圧にさらされると⽣育異常をきたすことを⾒いだしました。さらに、SLPはS. lividans の細胞内にとどまっており、特に細胞壁の合成が盛んな部位に蓄積する傾向があることも分かりました。このような局在性を決める要因を探ったところ、SLP がタンパク質合成装置であるリボソームの構成要素と相互作⽤し、細胞壁合成を担う重要なタンパク質とともに巨⼤な複合体を作っていることが⽰唆されました。つまり、SLP は細胞表層の構造維持に関与し、その結果としてS. lividans の浸透圧耐性に貢献していると考えられます。
本研究により、宿主⽣物(細菌)にとって有⽤なものとして、かつてウイルスだったものが獲得、保存された可能性が⽰されました。
PDF資料
プレスリリース研究代表者
筑波⼤学⽣命環境系永久保 利紀 助教
東京⼤学⼤学院農学⽣命科学研究科
尾仲 宏康 特任教授
⽇本⼤学⽣物資源科学部
⻄⼭ ⾠也 助教
掲載論文
- 【題名】
- Intracellular phage tail-like nanostructures affect susceptibility of Streptomyces lividans to osmotic stress
(細胞内ファージ尾部様構造体がStreptomyces lividans の浸透圧ストレス感受性に影響を与える) - 【掲載誌】
- mSphere
- 【DOI】
- 10.1128/msphere.00114-23


